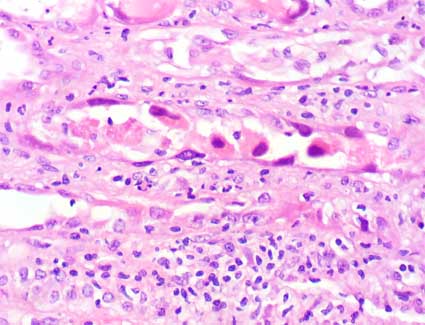
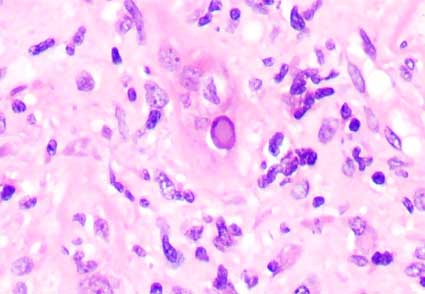
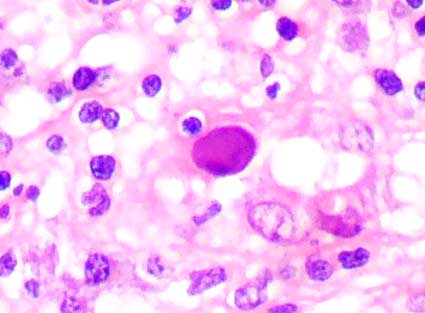
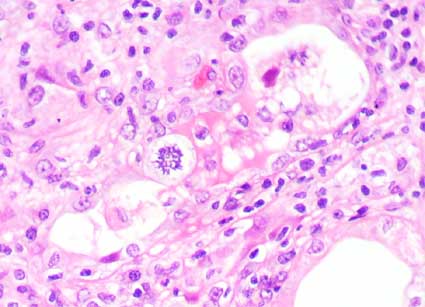

CASO
12
Datos clínicos
Mujer de 27 años de edad, trasplantada de riñón
cadavérico debido a falla renal terminal de causa desconocida.
La evolución en las primeras semanas del trasplante fue buena,
sin complicaciones. El tratamiento inmunosupresor consistió en
ciclosporina, micofenolato mofetil y prednisona. Tres meses después
del trasplante presenta elevación de la creatinina sérica:
3,0 mg/dL. No tenía episodios previos de rechazo. Proteinuria:
200 mg/dL; no hematuria. No presentaba síntomas sistémicos.
La ecografía renal no mostró alteraciones;
flujo arterial y venoso normales.
Con un diagnóstico presuntivo de rechazo agudo
se hace biopsia renal:

Figura 1.
H&E, X200.

Figura 2.
H&E, X200.
Figura 3.
H&E, X400.
Figura 4.
H&E, X400.
Figura 5.
H&E, X400.
Figura 6.
H&E, X400. (Lo más relevante no es la bonita mitosis)

Figura 7.
Plata-metenamina, X400.
Inmunohistoquímica para detectar C4d: negativa.
¿Cuál es su diagnóstico?
Ver
diagnóstico y discusión
[Arriba]
|